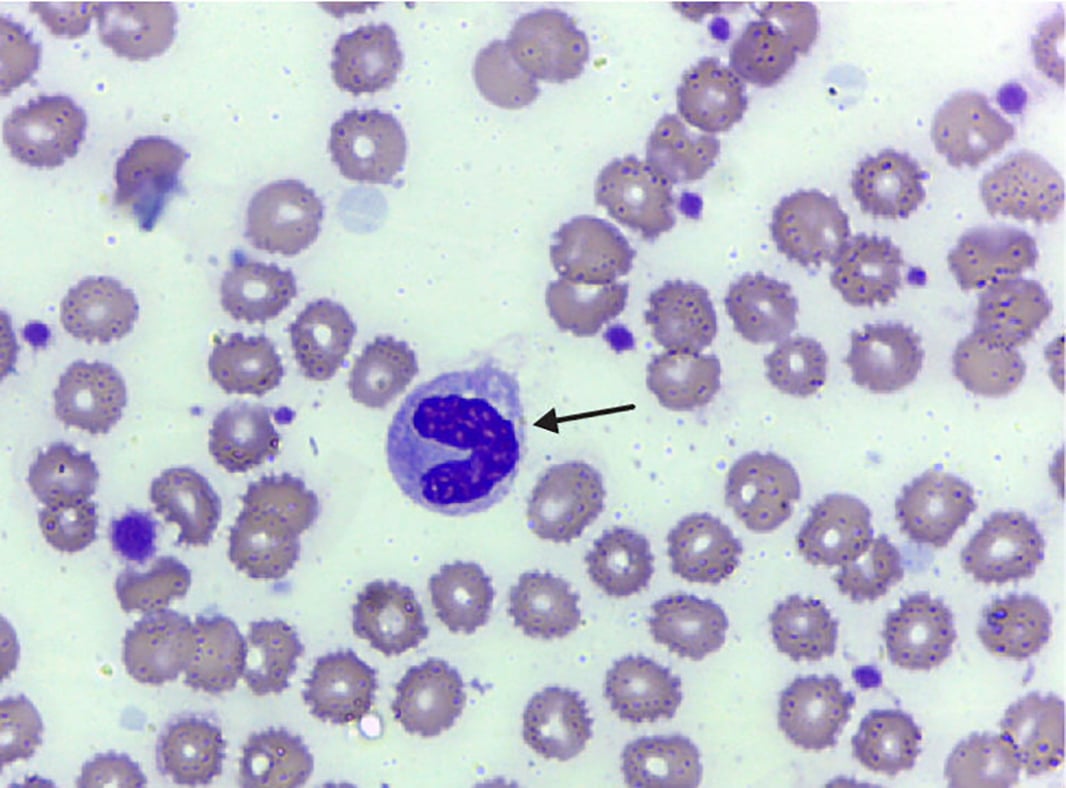

Neutrófilos
Os neutrófilos são glóbulos brancos essenciais do sistema imunitário, formando a primeira linha de defesa contra infeções, sobretudo bacterianas e fúngicas. Representam cerca de 50 a 70% dos leucócitos no sangue e são produzidos na medula óssea.
Principais características:
-
Núcleo segmentado em 2 a 5 lóbulos (polimorfo nuclear);
-
Citoplasma com grânulos contendo enzimas, proteínas antimicrobianas e radicais livres;
-
Migração rápida para locais de infeção (quimiotaxia);
-
Presença de pseudópodes e recetores de superfície;
-
Vida curta: algumas horas no sangue, 1–2 dias nos tecidos;

Função principal:
-
Fagocitose de microrganismos, células mortas e detritos celulares
-
Libertam citocinas, enzimas e radicais livres para reforçar a resposta imunitária
-
Participam na inflamação e cicatrização
-
Após a fagocitose, morrem por apoptose
Subtipos e funções específicas:
-
Neutrófilos circulantes → Sangue → Migram para locais de infeção quando ativados
-
Neutrófilos residentes → Tecidos → Vigilância e resposta rápida a infeções locais
-
Neutrófilos ativados → Tecidos → Fagocitose, libertação de enzimas e radicais livres, formação de NETs
Outras funções importantes:
-
Recrutam outras células imunitárias para o local da infeção
-
Eliminam células mortas e detritos nos tecidos
-
Mantêm a integridade tecidular e protegem o organismo contra patogénicos
Papel na imunidade:
-
Fundamentais na resposta imunitária inata, controlando infeções e iniciando a cicatrização
-
Uma atividade excessiva ou insuficiente pode provocar desequilíbrios imunológicos, aumentando a vulnerabilidade a infeções ou inflamações crónicas